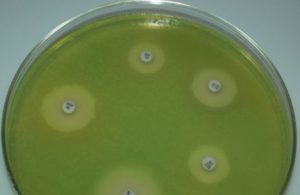
Pseudomonas aeruginosa growing on Mueller Hinton Agar - Pseudomonas aeruginosa(green color) growing onMueller Hinton Agar
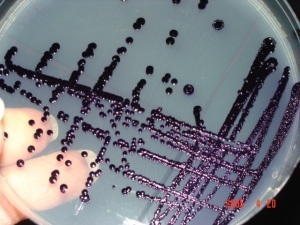
Characteristics pigment production by Chromobacterium violaceum - Characteristics pigment production byChromobacterium violaceum

Some pathogenic microorganisms when propagated in a culture medium give distinctive colors to their colonies. Such pigmentation comes in a variety of hues and often provides important diagnostic clues in laboratories for the identification of the isolates. These microbial pigments also play a role in disease pathogenesis by interfering with host immune clearance mechanisms or by exhibiting pro-inflammatory or cytotoxic properties.
Pseudomonas species
Pseudomonas aeruginosa is a leading bacterial pathogen in hospital settings and for immunocompromised patients (those with underlying conditions such as neutropenia, burns, or cystic fibrosis). P. aeruginosa (aeruginosa, which derives from a Latin word denoting the color of copper rust) produces a green fluorescent pigment (fluorescein/pyoverdin) and a blue pigment (pyocyanin). These pigments impart a greenish hue to the sputum of cystic fibrosis patients with a chronic lung infection, giving colonies and infected wound dressings a greenish-blue coloration.
P. aeruginosa is usually recognized by the pigments it produces and the distinctive smell of cultures. . When the culture is left at room temperature, pigment color becomes more intense.  A minority of strains are non-pigment producing. Other species of Pseudomonas (such as P.fluorescens and P. putida) also produce pigments.
Serratiamarcescens

Serratiamarcescens (mnemonic: Mars is red) is notable for its production of a bright red pigment called “prodigiosin”. Some strains produce a red pigment in nutrient agar at room temperature
Staphylococcus aureus
Staphylococcus aureus (aureus = “golden”, Latin) produces multiple carotenoid pigments, one being golden-yellow pigment (Staphyloxanthin). When cultured on sheep blood agar, S. aureus can be differentiated from other beta-hemolytic cocci by elaboration of golden pigment. The pigment is less pronounced in young colonies.
Violacein fromChromobacterium violaceum
Chromobacterium violaceum**,** an agent of localized skin infection or localized lymphadenitis which occasionally causes fatal septicemia elaborates a blue-violet pigment, violacein.
Group B Streptococcus
Group B Streptococcus (GBS), the leading etiologic cause of severe neonatal bacterial infection, expresses an orange-red pigment, called **granadaene.**This orange pigment is produced by Streptococcus agalactiaewhen cultured on serum starch agar anaerobically.
Iron porphyrin ofPorphyromonas gingivalis
Porphyromonas gingivalis is a gram-negative anaerobic bacilli, which is implicated in the pathogenesis of certain forms of periodontal disease. Arginine- and lysine-specific gingipain proteases of P. gingivalis degrade hemoglobin to release iron (III) protoporphyrin IX, which is dimerized to form the micro-oxo bis-haem-containing black pigment of the organism.
Nontuberculous Mycobacteria
The genus Mycobacterium includes many bacteria that produce pigments. The Runyon classification system groups mycobacteria based on growth rate and pigment production in the presence of light or dark. M. tuberculosis is a nonchromogen, i.e. it does not produce pigment in light or darkness
Fungal pathogens which produce pigments
Aspergillus fumigatusis a filamentous fungus that elaborates a melanin-like substance during its conidial stage of growth.
Cryptococcus neoformans is an encapsulated yeast-like fungus that produces a brown or black melanin pigment by conversion of diphenols or homogentisic acid this coloration can be used for rapid identification of colonies on cornmeal agar, a medium commonly used in yeast isolation
Talaromyces marneffei(formerly called Penicillium marneffei) is an opportunistic pathogen causing systemic penicilliosis in AIDS patients. It produces characteristic red pigment in sabouraud dextrose agar.
References
- Madigan Michael T, Bender, Kelly S, Buckley, Daniel H, Sattley, W. Matthew, & Stahl, David A. (2018). Brock Biology of Microorganisms (15th Edition). Pearson.
- Mohammadi, M., Burbank, L., & Roper, M. C. (2012). Biological role of pigment production for the bacterial phytopathogen Pantoea stewartii subsp. stewartii. Applied and environmental microbiology, 78(19), 6859–6865. https://doi.org/10.1128/AEM.01574-12